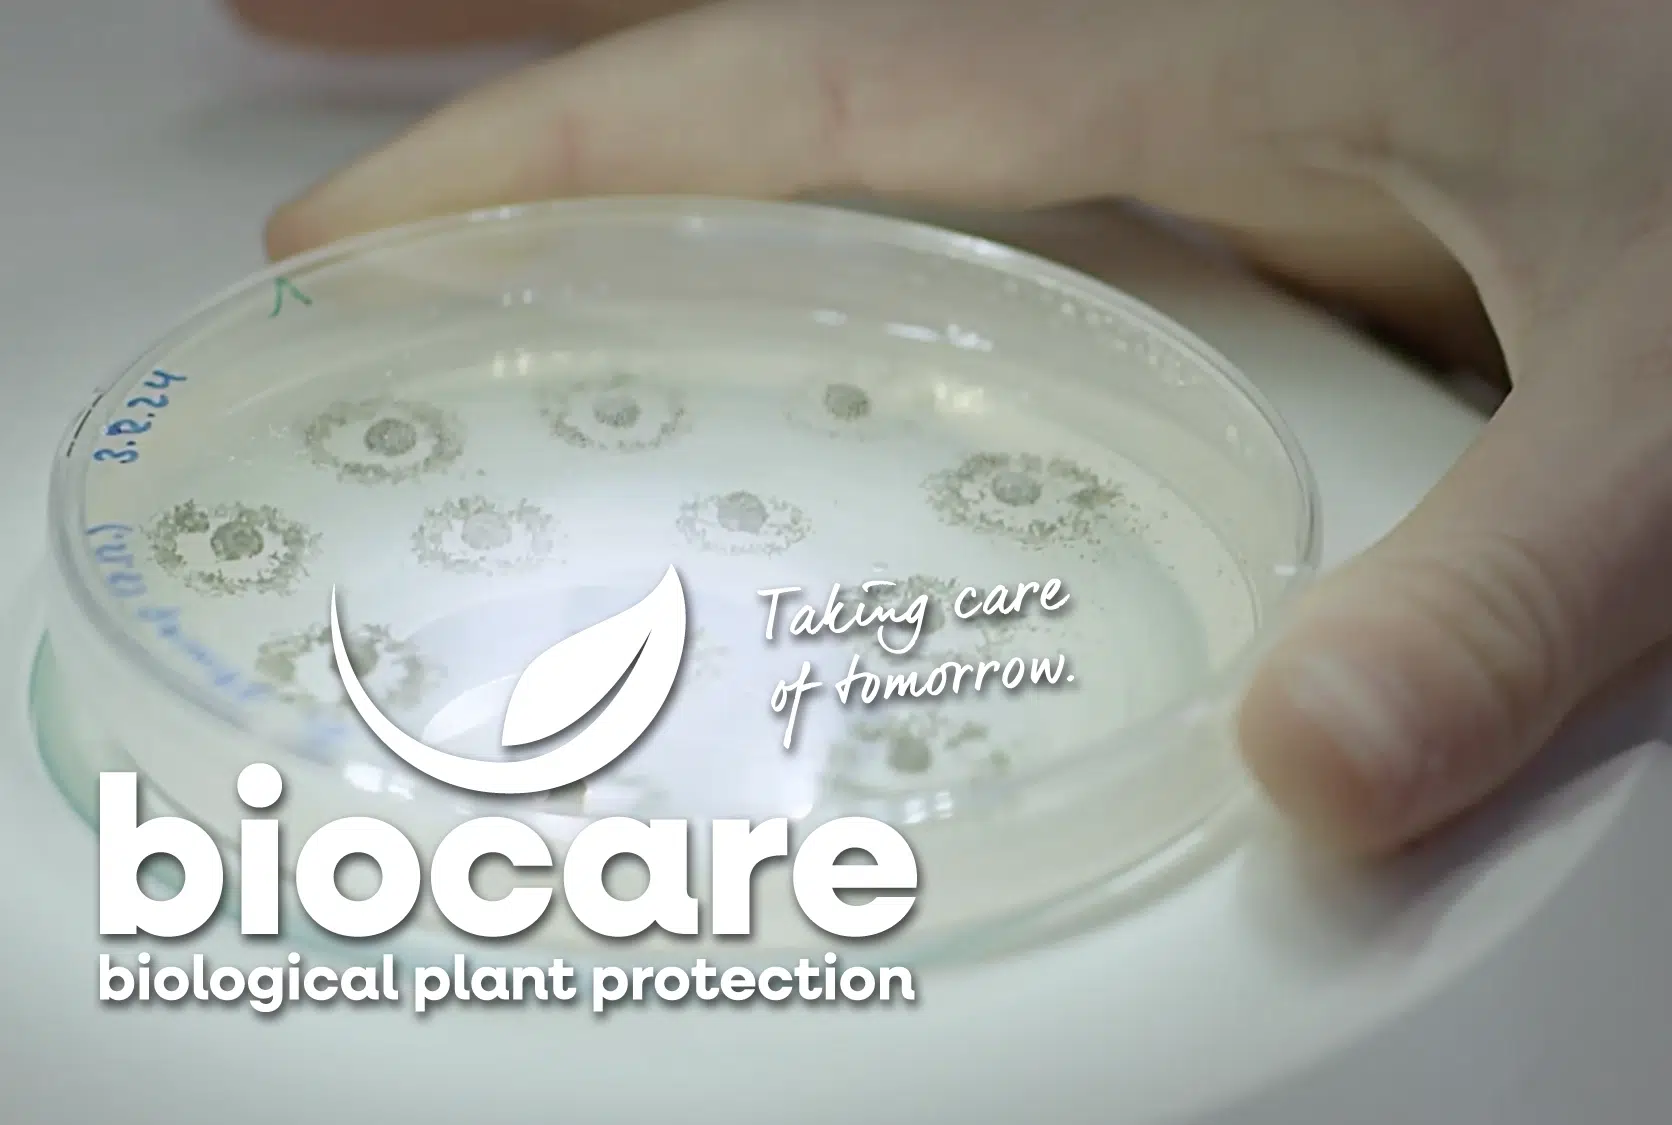
BIOCARE_Header 4

Unsere Mission
Biologischer Pflanzenschutz für maximalen Ertrag und hohe Artenvielfalt
Biologischer Pflanzenschutz für maximalen Ertrag und hohe Artenvielfalt steht im Mittelpunkt unseres unternehmerischen Denkens und Handelns.
Bereits seit 1995 entwickeln wir für unsere Kunden wirksamen, umweltfreundlichen Pflanzenschutz – für gesunde Lebensmittel, nachhaltige Landwirtschaft und eine Zukunft im Einklang mit der Natur.
Mit diesen mehr als 30 Jahren Erfahrung, innovativen Produkten und tiefem Fachwissen sind wir europaweit ein verlässlicher Partner für Landwirte, die mehr wollen: Ertrag, Verantwortung und Biodiversität.
Unsere Produkte
Natürlich funktioniert’s
ATTRACAP®
Mikrobieller Schutz gegen den Drahtwurm im Kartoffel- und Spargelanbau
Biocare aktuell
Neues für Kunden, Anwender, Forschungspartner
Wechsel in der Vertriebsleitung
Herr Dirk Gerstenkorn (l.) übernimmt ab sofort die Position des Vertriebsleiters bei Biocare von Herrn Pawel Domeracki (r.). Herr Gerstenkorn bringt langjährige Erfahrung in der Landwirtschafts- und Saatgutbranche mit. Bei Herrn Domeracki bedanken wir uns herzlich für die vertrauensvolle Zusammenarbeit und seinen großen Einsatz. Er wird weiterhin den polnischen Markt für uns betreuen.
Neues Unternehmens-Logo,
gleiche Haltung.
Unser Unternehmensauftritt hat anlässlich unseres 30-jährigen Geburtstags ein frisches Gesicht bekommen – klarer, moderner, zukunftsgerichtet.
Was bleibt? Unsere Werte, unser Anspruch und unsere Überzeugung, dass durch biologischen Pflanzenschutz ertragreiche und gesunde Lebensmittelproduktion im Einklang mit der Natur möglich ist!
Wir feiern Jubiläum:
30 Jahre Biocare
Seit 1995 denken wir biologischen Pflanzenschutz neu.
Weil wir überzeugt sind: Die Gesundheit von Mensch und Umwelt gehört untrennbar zusammen.
2025 feiern wir 30 Jahre Innovation, Verantwortung und echtes Engagement. Freuen Sie sich auf ein Jubiläumsjahr voller starker Aktionen – für unsere Umwelt und für unsere Mitarbeitenden. Auf Instagram geben wir jeden Monat Einblicke hinter die Kulissen: Projekte, Ideen, Menschen.